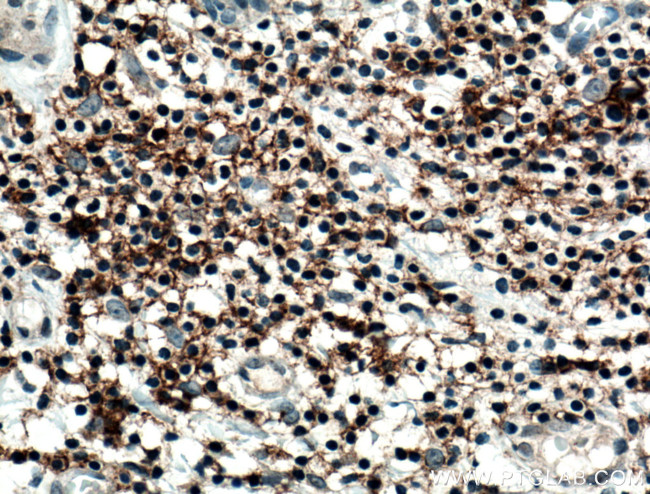
CD82 Antibody in Immunohistochemistry (Paraffin) (IHC (P))

Search
Proteintech
CD82 Polyclonal Antibody
{{$productOrderCtrl.translations['antibody.pdp.commerceCard.promotion.promotions']}}
{{$productOrderCtrl.translations['antibody.pdp.commerceCard.promotion.viewpromo']}}
{{$productOrderCtrl.translations['antibody.pdp.commerceCard.promotion.promocode']}}: {{promo.promoCode}} {{promo.promoTitle}} {{promo.promoDescription}}. {{$productOrderCtrl.translations['antibody.pdp.commerceCard.promotion.learnmore']}}
产品信息
10248-1-AP
种属反应
宿主/亚型
分类
类型
抗原
偶联物
形式
浓度
规格
纯化类型
保存液
内含物
保存条件
运输条件
产品详细信息
Immunogen sequence: LADKSSFIS VLQTSSSSLR MGAYVFIGVG AVTMLMGFLG CIGAVNEVRC LLGLYFAFLL LILIAQVTAG ALFYFNMGKL KQEMGGIVTE LIRDYNSSRE DSLQDAWDYV QAQVKCCGWV SFYNWTDNAE LMNRPEVTYP CSCEVKGEED NSLSVRKGFC EAPGNRTQSG NHPEDWPVYQ EGCMEKVQAW LQENLGIILG VGVGVAIVEL LGMVLSICLC RHVHSEDYSK V (35-264 aa encoded by BC000726)
靶标信息
This metastasis suppressor gene product is a membrane glycoprotein that is a member of the transmembrane 4 superfamily. Expression of this gene has been shown to be downregulated in tumor progression of human cancers and can be activated by p53 through a consensus binding sequence in the promoter. Its expression and that of p53 are strongly correlated, and the loss of expression of these two proteins is associated with poor survival for prostate cancer patients. Two alternatively spliced transcript variants encoding distinct isoforms have been found for this gene.
仅用于科研。不用于诊断过程。未经明确授权不得转售。
生物信息学
蛋白别名: C33 antigen; CD82; CD82 antigen; IA4; Inducible membrane protein R2; KAI1; kangai 1 (suppression of tumorigenicity 6, prostate); kangai 1 (suppression of tumorigenicity 6, prostate; CD82 antigen (R2 leukocyte antigen, antigen detected by monoclonal and antibody IA4)); Metastasis suppressor Kangai-1; Metastasis suppressor Kangai-1 homolog; Suppressor of tumorigenicity 6 protein; Tetraspanin-27; Tspan-27; type III integral membrane protein; unnamed protein product
基因别名: 4F9; AA682076; AL023070; C33; CD82; GR15; IA4; KAI1; R2; SAR2; ST6; TSPAN27
UniProt ID: (Human) P27701, (Mouse) P40237
Entrez Gene ID: (Human) 3732, (Mouse) 12521